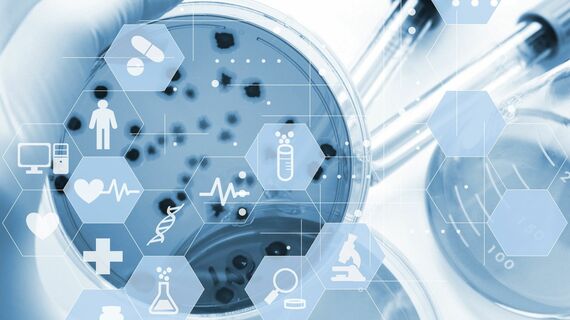

「ドンネルの男」の異名
北里柴三郎はこのたび発行の新千円札の肖像に採用された。
北里柴三郎(1853~1931)は日本近代医学の父である。世界に先がけて破傷風菌の純粋培養に成功し、その抗毒素も発見、血清療法の基礎を築いた。さらに、ペスト菌も発見、世界に知られた細菌学者である。
北里は東京大学医学部の学生時代に著した演説会用原稿『医道論』の中で、「医者の道とは病気を未然に防ぐ事」と主張し、「予防衛生・国利民福」を生涯の目標として細菌学の研究に邁進した。この初心を北里は生涯をかけて貫いた。「終始一貫(しゅうしいっかん)」は北里の座右銘である。まさに、終始一貫して、国の衛生事業に生涯を捧げたのである。
指導者となった北里が門人に放つドンネル(ドイツ語で雷の意味)は有名だった。失敗や怠慢などに容赦のない雷が落ち、その大声での怒鳴り声は研究所内に響き渡った。そこには、悪気や私心はなく、一喝の後は、晴天が待っていた。腹蔵なく雷を落とすことでストレスを発散させていた可能性があり、北里の健康術の基本はここにあったのかもしれない。












